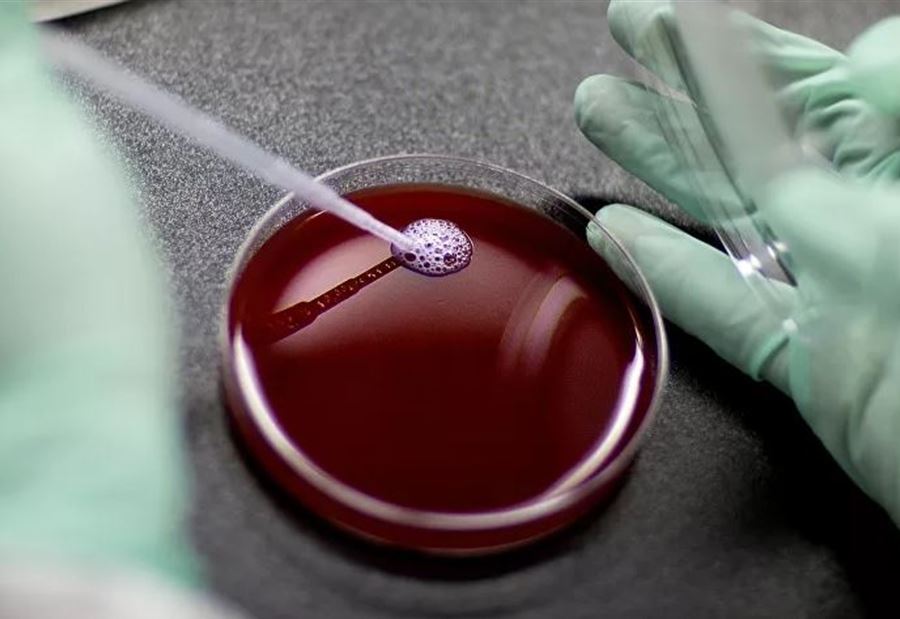

اكتشف فريق دولي من مجموعة علماء مرض يسمى VEXAS، يمكن أن يكون قاتلا للبالغين.
ظهرت نتائج الدراسة في 27 تشرين الأول في مجلة The New England Journal of Medicine.
كما توصلت الدراسة إلى أن المرض يترافق مع تكوين جلطات دموية ويمكن أن يكون قاتلا في 40٪ من الحالات.
يعتقد العلماء أن سبب تطور مرض VEXAS هو الطفرات الجسدية في جيناتUBA1. وغالبًا ما يصاب مثل هؤلاء المرضى بمتلازمة التهابية قاتلة، مصحوبة بالحمى وتشكل خثرات بشكل نشط والتهاب في أنسجة الغضاريف والرئة.
وقالت الدراسة "تم العثور على طفرات في أكثر من نصف الخلايا الجذعية المكونة للدم، بما في ذلك خلايا الدم النخاعية، ولكن ليس الخلايا الليمفاوية أو الخلايا الليفية".
لاحظ العلماء أن المرض المستجد يوحد، كما كان يعتقد سابقًا، متلازمات التهابية غير مرتبطة عند البالغين.
وتمكن الباحثون من تحديد 50 مريضًا فقط بهذا المرض، لكن من المحتمل أن يكون هناك المزيد منهم.
تــابــــع كــل الأخــبـــــار.
إشترك بقناتنا على واتساب

Follow: Lebanon Debate News

الـــمــــزيــــــــــد
الـــمــــزيــــــــــد





